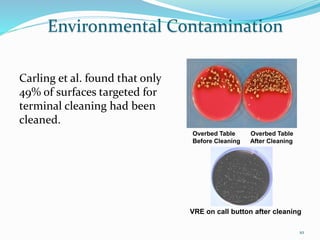
Carling et al. found that only
49% of surfaces targeted for
terminal cleaning had been
cleaned.
Overbed Table Overbed Table
Before Cleaning After Cleaning
VRE on call button after cleaning
Environmental Contamination
10

The document discusses the significant role of environmental contamination in the transmission of healthcare-associated pathogens in hospitals, including MRSA and C. difficile. It highlights challenges in cleaning practices, the duration pathogens can survive on surfaces, and the effectiveness of various disinfection methods, such as UV light and hydrogen peroxide. Recommendations include improving cleaning protocols, staff training, and the use of advanced disinfection technologies to reduce infection risks.

![Environmental Contamination
There is excellent evidence in the scientific
literature that environmental contamination plays
an important role in the transmission of several
key healthcare-associated pathogens.
Including methicillin-resistant Staphylococcus
aureus [MRSA] , vancomycin-resistant
Enterococcus [VRE], Acinetobacter, norovirus, and
Clostridium difficile.
2](https://image.slidesharecdn.com/newtechnologiesinenvironmentalcleaning-160330051223/85/New-technologies-in-environmental-cleaning-2-320.jpg)